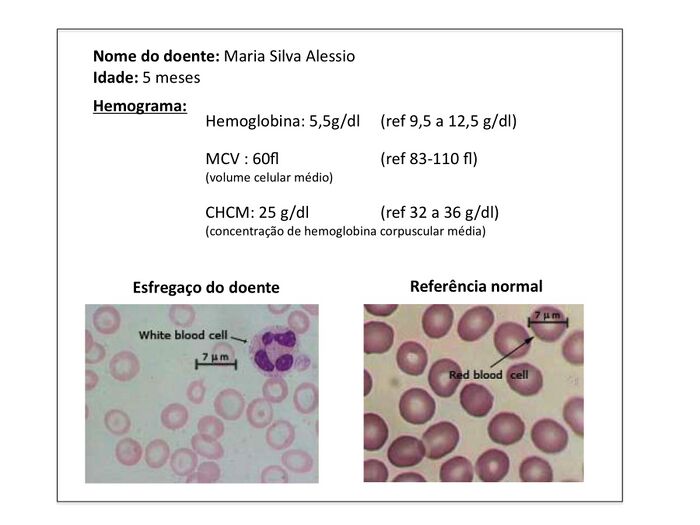

BIOMOL LCS/2010:Caso1.1: Difference between revisions
No edit summary |
No edit summary |
||
| Line 69: | Line 69: | ||
[[Image:BIOMOL_LCS_Dados3.jpg|700px]] | [[Image:BIOMOL_LCS_Dados3.jpg|700px]] | ||
Depois de um dia em ansiedade crescente, finalmente chegou a hora da consulta. A Filipa tremia de nervoso quando a Dra. Teresa apareceu e conduziu o casal para o pequeno gabinete medico. | Depois de um dia em ansiedade crescente, finalmente chegou a hora da consulta. A Filipa tremia de nervoso quando a Dra. Teresa apareceu e conduziu o casal para o pequeno gabinete medico. | ||
Revision as of 01:07, 16 March 2010
Parte 1. Expressão da informação
Caso de Estudo 1 – A herança da Maria
A Filipa e o Pietro estavam a viver um período muito especial: os primeiros dias em casa com a sua filha recém-nascida Maria. A bébé era linda e rosadinha, comia bem, dormia bem, enfim, tudo corria na perfeição para estes pais de primeira vez. Aquele princípio de Junho parecia perfeito. O Pietro pegou as férias à licença de paternidade para puder acompanhar de perto as suas “meninas”, os avós vieram de Itália, e toda a família se juntou no Algarve, onde os pais da Filipa viviam, para uns dias de Verão inesquecíveis.
Foi com a chegada dos primeiros dias de frio e chuva, que algo mudou. Primeiro foram as rezinguices da avó Joaquina, que achava que a neta não engordava como devia. Os pais riam-se, dizendo que a Maria saía à mãe, pequenina e magrinha mas, no íntimo, não deixavam de se interrogar. Pouco depois, a bébé começou a perder o apetite, a ficar pálida e com pouca energia. Preocupados, os pais decidiram leva-la à pediatra. Depois de um exame de rotina, a Dra. Teresa descansou-os:
- Parece um síndrome viral típico da época, tenho visto muitas crianças assim nos últimos dias, algumas fazem febre baixa, mas nada mais. Vamos aguardar alguns dias mais e, por certo, para a semana ela já vai estar melhor. Alguma dúvida, liguem para o consultório.
- Obrigada Doutora. Também achámos que não devia ser nada de especial, mas preferimos ouvir a sua opinião - disse a Filipa.
No entanto, ao fim de quase uma semana a Maria não tinha recuperado. Quinta-feira, a Filipa ligou para o consultório e a Dra. Teresa disse que passassem por lá no dia seguinte, para examinar novamente a Maria. Desta vez, a conversa foi diferente.
- Bem, de facto a Maria já devia ter recuperado por esta altura. E ela tem o baço algo aumentado. Isto pode ser o resultado de um esforço extra do orgão no combate a uma infecção, mas também pode indicar outro tipo de doença.
- Diga-me uma coisa Pietro, de que parte da Itália é a sua família?
- Da Apulia, no sul, Doutora. Mas porquê?
- Curiosidade, mera curiosidade. Um sítio que ainda não conheço, veja lá. A Filipa é algarvia, certo?
- Dois jovens de terras quentes, disse a doutora com um sorriso reconfortante.
- Bom, gostava de fazer umas análises à Maria para tentarmos perceber rapidamente o que se passa. Se forem já ao laboratório de colheitas, ainda lhe tiram o sangue hoje e na segunda-feira já teremos os resultados. Eles têm muito jeito a lidar com crianças, a Maria nem vai dar por nada. Os resultados vêm directamente para mim e na segunda eu ligo-lhes a dar notícias. Entretanto, aproveitem o fim-de-semana para descansar, que para já não vale a pena estarem preocupados.
- Muito bem Dra. Teresa, assim faremos. E obrigada pela disponibilidade, disse a Filipa, sentindo-se reconfortada por um acompanhamento tão próximo.
- É para isso que estamos aqui, para esta princesinha ficar mais animada, disse a Dr. Teresa enquanto fazia cócegas na barriga da Maria, que se ria contente com a atenção.
Continuação:
O resultado das análises.
Segunda-feira logo de manhã o telemóvel da Filipa tocou, indicando número privado.
- Estou?
- Bom dia Filipa, fala a Dra. Teresa.
- Bom dia, Dra. Imagino que me esteja a ligar por causa das análises da Maria.
- Sim, é verdade. Logo à tarde estou de serviço no hospital e queria que fossem lá ter comigo para falarmos. Mas entretanto, era importante passarem os três ainda de manhã na laboratório de hematologia do hospital, para fazerem novos exames, disse a Dra. Teresa.
- Mas o que se passa, Dra.? Estou a ficar preocupada…
- Bom, eu preferia falar convosco pessoalmente. Mas posso já adiantar-lhe que as análises indicaram que a Maria tem uma anemia grave e gostaria de despistar a possibilidade de ser de origem hereditária. É fundamental termos exames mais detalhados para podermos iniciar um tratamento o quanto antes.
- Mas…
- Filipa, eu sei que isto tudo soa um pouco assustador, mas por favor confie em mim. Eu já deixei um pedido de exames no laboratório e espero-vos logo ao fim da tarde na urgência de pediatria para conversarmos sobre o estado da Maria.
- Muito bem Dra. Teresa. Vamos agora tratar das análises e logo iremos ter consigo. Obrigada por tudo.
- Até logo, Filipa. E não se inquiete, que vamos fazer tudo o que for possível para ajudar a Maria.
Depois de um dia em ansiedade crescente, finalmente chegou a hora da consulta. A Filipa tremia de nervoso quando a Dra. Teresa apareceu e conduziu o casal para o pequeno gabinete medico.
- Como estão?
- Imagino que ansiosos com tudo isto, disse a Dra. Teresa. Vou-lhes pedir que me escutem com calma e atenção, porque as notícias que tenho para vos dar são um pouco dificeis.
- Somos todos ouvidos, Dra., disse o Pietro, enquanto tranquilizava a sua mulher pousando a mão pousada no seu ombro.
- Bem, os resultados das análises revelaram que a Maria sofre de uma doença hereditária chamada beta-talassémia. Trata-se de uma deficiência grave na produção de hemoglobina, que a impede de produzir glóbulos vermelhos com capacidade de fazer o transporte de oxigénio no sangue de forma eficiente. É uma situação grave, como podem perceber, mas para a qual temos algumas opções terapêuticas.
- Mas, como pode ser isso, perguntou a Filipa inquieta. A Maria nasceu tão saudável! E nós não temos problema de saúde nenhum!
- É verdade Filipa. Mas a produção da forma de hemoglobina presente nos adultos só está completa por volta dos seis meses. E vocês os dois tiveram a infelicidade de serem portadores silenciosos do gene, e de o transmitirem à Maria.
- Vou dar-vos este folheto informativo sobre a doença e as opções terapeuticas disponíveis, mas a Maria tem de começar imediatamente a receber transfusões de sangue para compensar a falta de hemoglobina.
- Entretanto, pedi ao laboratório de Biologia Molecular análises para a identificação concreta da alteração genética causadora da doença. Começam actualmente a existir terapias experimentais alternativas que podem beneficiar doentes com certas características genéticas.
- Vamos conversando sobre o assunto enquanto vos acompanho até à Unidade de Pediatria…